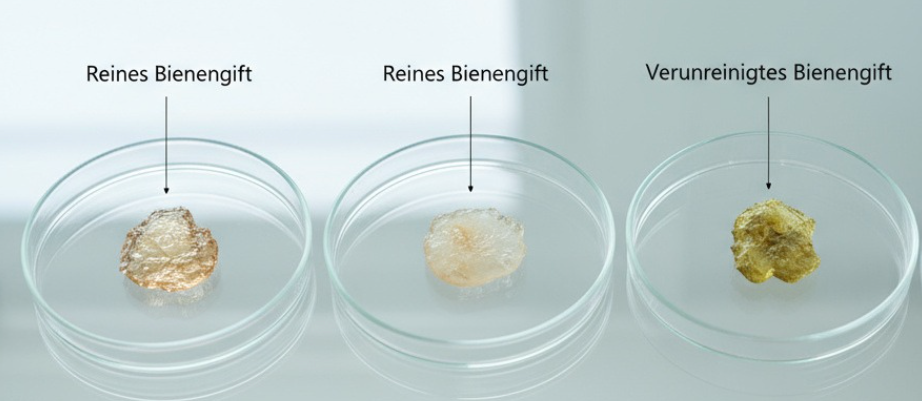

Produkte aus der Natur > Bienengift
Bienengift-Salben Testsieger 2025: Fachexpertise und echte Imkerei-Erfahrung seit 1844
Der Unterschied im Bienengift – auf diese Qualitätskriterien sollten Sie achten!
Wer nach einer Bienengift-Salbe sucht, erwartet Linderung bei Schmerzen, Verspannungen oder Gelenkbeschwerden.
Doch viele Produkte halten nicht, was sie versprechen – oft, weil das verwendete Bienengift von minderer Qualität ist.
Wir haben verschiedene Salben getestet und dabei große Unterschiede festgestellt.


Wozu Bienengift genutzt wird
Schon seit Jahrhunderten wird Bienengift zur Behandlung von Schmerzen in Muskeln und Gelenken verwendet. Es gilt als vielseitig einsetzbar, natürlich und daher besonders gut verträglich.

Muskelverspannungen
Bienengift kann helfen, die lokale Durchblutung zu fördern und verspannte Muskeln zu lockern.

Arthrose & Gelenkschmerzen
Es wird traditionell eingesetzt, um Schmerzen und Entzündungen in beanspruchten Gelenken zu lindern.

Rheuma
Durch die durchblutungsfördernden und entzündungshemmenden Eigenschaften kann Bienengift das Wohlbefinden bei rheumatischen Beschwerden verbessern.

Hexenschuss & Rückenprobleme
Eine wahlweise wärmende oder -kühlende Wirkung entspannt jeweils die betroffene Muskulatur und fördert die Regeneration.

Kalkschulter
Auch bei chronischen Schulterbeschwerden kann Bienengift helfen, Spannungen zu lösen, Ablagerungen zu beseitigen und die Beweglichkeit zu verbessern.
So haben wir Getestet:
Unsere Redaktion hat mehrere Bienengift-Salben in Laboranalysen und Praxistests miteinander verglichen. Entscheidend waren Qualität, Natürlichkeit der Zusammensetzung, Reinheit und Hautverträglichkeit.
Das Ergebnis war eindeutig: Die ECHTE Bienengift-Salbe API-REGENT® aus der Traditionsimkerei Schloßwald-Bienengut® ging als klarer Testsieger hervor.

Qualität, die den Unterschied macht

Bei Bienengift-Salben ist die Qualität des verarbeiteten Giftes der Schlüssel zur Wirksamkeit.
Der entscheidende Faktor heißt Melittin – dies ist die zentrale Wirksubstanz des Bienengiftes, die maßgeblich für seine schmerzlindernde, durchblutungsfördernde und entzündungshemmende Wirkung verantwortlich ist. Während minderwertiges Bienengift oft nur 40–55 % Melittin enthält, erreicht die ECHTE Bienengift-Salbe API-REGENT® Werte von mindestens 60–70%, zumeist sogar weit über 70 % im Test.
Denn der Melittin-Anteil in einer hochwertigen Bienengiftsalbe sollte idealerweise im Bereich von mindestens 60–70 % liegen; Melittin ist der Hauptbestandteil des Bienengifts und macht den eigentlichen Wirk-Effekt aus. Nur bei Anteilen in diesem Bereich kann Bienengift seine volle schmerzlindernde und entzündungshemmende Wirkung zuverlässig entfalten.
Diese Reinheit sorgt für eine deutlich effektivere Wirkung, ohne die Haut zu reizen. Alle Inhaltsstoffe sind 100 % natürlich, dermatologisch getestet und frei von chemischen Zusätzen.
Laborstandard: Bienengift in Premium-Qualität
Das Bienengift der API-REGENT®-Salbe erfüllt höchste Laborstandards. Jede Charge wird auf Reinheit, Färbung und Melittin-Gehalt auf medizinischem Niveau geprüft.
Die Farbe ist bereits bei der Ernte ein entscheidender Qualitätsindikator:
Nur champagnerfarbenes bis reinweißes Bienengift zeigt eine hohe Reinheit und einen optimalen Melittin-Anteil zwischen 60 % und 70 %. Grünlich oder gelb verfärbtes Bienengift hingegen deutet auf Verunreinigungen und geringeren Wirkstoffgehalt hin. Diese hohe Qualität spiegelt sich auch in der besonders angenehmen, tiefenwirkenden Anwendung wider.
Wie Reinheit und Güte garantiert werden
Viele Hersteller greifen bei der schnellen Gewinnung von Bienengift auf einfache Stromfallen vor den Fluglöchern der Bienenvölker zurück.
Besonders neue Marken ohne eigene Imkerei-Erfahrung oder mit industrieller Produktion setzen häufig auf diese Methode, weil sie kostengünstig und zeitsparend ist.
Dabei werden überwiegend ältere Flugbienen zum Stechen animiert – genau jene Tiere, die im Laufe ihres Lebens die meisten Umweltbelastungen aufgenommen haben. Das daraus gewonnene Gift ist oft gelblich bis grünlich verfärbt, enthält nur rund 40–55 % Melittin und weist deutlich geringere Wirkkraft auf.
Die Herstellung der API-REGENT®-Salbe erfolgt dagegen ausschließlich aus Bienengift, das mit einer patentierten, sanften Methode gewonnen wird.
Anders als bei der massenhaften Ernte mit Stromfallen setzt das Schloßwald-Bienengut® auf Glas-Kuppeln über den Stöcken, in denen junge Ammenbienen arbeiten.
Sie liefern ein naturreines, nicht verunreinigtes Gift. Durch die sorgfältige Beachtung von Wetter, Tageszeit und Mondphase entsteht ein Rohstoff von höchster Reinheit.
Bienen kommen dabei nicht zu Schaden

Ein weiterer Grund, warum API-REGENT® überzeugt: Die Bienen bleiben unversehrt.
Bei der sanften Ernte geben sie ihr Gift ab, ohne zu sterben – ein ethisch und ökologisch vorbildlicher Prozess. Diese nachhaltige Methode schont die Bienenvölker und garantiert gleichzeitig ein reines, kraftvolles Naturprodukt.
Hinter dieser Expertise steht im Gegensatz zu allen Vergleichsprodukten kein Großhandel, sondern tatsächlich noch eine echte, schwäbische Familien-Imkerei mit über fünf Generationen Erfahrung in der Bienenzucht und der Verarbeitung naturreiner Rohstoffe – ein Wissen, das in jeder Salbe spürbar ist.
Wer also nach einer tatsächlich wirksamen und verantwortungsvoll hergestellten Bienengift-Salbe sucht, findet im Testsieger API-REGENT® die beste Wahl.



99,98% der Anwender lieben dieses Produkt
Unser Testsieger 2025
(4,86/5) ⭐️⭐️⭐️⭐️⭐️ 598 Bewertungen
API-REGENT® Die ECHTE Bienengift-Salbe
Naturreine Bienengift-Salben zur äußerlichen Anwendung
ab 25,99€ statt 34,90€
Dermatologisch & klinisch getestetes Naturprodukt
100% Made in Germany
ohne chemische Stabilisatoren & Konservierungsmittel
Hier erhältlich
27,40 €
29,99 €

31,41 €
28,55 €

25,99 €

29,99 €

PZN
13694978

Darreichung
Salbe

Hersteller
Schloßwald-Bienengut GmbH & Co. KG
Produktinformationen
Api-Regent Bienengift-Salbe Die perfekt abgestimmte Grund-Basis maximal dosierter, feinster ätherischer Öle, wird in ihrer Rezeptur durch die effektive Naturkraft von reinstem Bienengift verstärkt. Die hochwertige, 100 % rein natürliche Rezeptur von „die ECHTE Bienengift-Salbe API-REGENT®“ verzichtet auf wärme fördernde Wirkstoffe und wird daher auf der Haut sehr angenehm und eher kühlend wahrgenommen.
Api-Regent - das patentierte Original
Feinste Naturkosmetik. Frei von Mineralölen. Frei von Parabenen. Ohne synthetische Zusatzstoffe. Dermatologisch und klinisch getestet. 100% Made in Germany. Anwendung: Api-Regent von außen auf die gewünschten Stellen auftragen und sanft in die Haut einmassieren. Aufgrund ihrer reichhaltigen Textur ätherischer Öle zieht die Salbe ansonsten langsam ein und entfaltet ihre Kräfte langanhaltend. Produkt nicht mit Augen und Schleimhäuten in Kontakt bringen! Obwohl es sich hier um ein Produkt aus rein natürlichen Inhaltsstoffen handelt, kann bei besonders empfindlichen Personen im Einzelfall eine allergische Reaktion (z.B. Rötungen oder Juckreiz) nicht ausgeschlossen werden. Daher empfehlen wir die Salbe vor einer flächendeckenden Anwendung zuerst an einer kleinen unauffälligen Hautpartie zu testen.
Allergikerhinweis: Bei bereits bekannter Unverträglichkeit gegen einen der Inhaltsstoffe, sollte dieses Produkt nicht verwendet werden.
Nach Anbruch der Tube ist die Salbe noch 12 Monate bei Zimmertemperatur haltbar.
Lanolin, Prunus Amygdalus Dulcis (Sweet Almond) Oil, Olus ( Vegetable ) Oil, Aqua [Water], Juniperus Communis Fruit Oil, Cera Alba [Beeswax], Rosmarinus Officinalis (Rosemary) Leaf Oil, Melaleuca Leucadendron Leaf Oil, Polyglyceryl-3 Polyricinoleate, Mentha Piperita (Peppermint) Oil, Thymus Vulgaris Oil, Camphor, Magnesium Sulfate, Menthol, Tocopheryl Acetate, Limonene, Eucalyptus Globulus Leaf Oil, Eugenia Caryophyllus (Clove) Leaf Oil, Hydrogenated Castor Oil, Pinus Sylvestris Leaf oil, Eugenol, Benzyl Alcohol, Linalool, Lactic Acid, Sodium Benzoate, Potassium Sorbate, Geraniol, Apitoxin.
Kundenbewertungen zu API-REGENT® Die ECHTE Bienengift-Salbe

Das erste Produkt, das wirklich hilft
von Sabine K. vor 9 Tagen
Ich habe schon mehrere Bienengift-Salben gegen meine Athrose Beschwerden ausprobiert, aber keine hat so gut gewirkt wie die API-REGENT®. Schon nach wenigen Anwendungen waren meine Knie beweglicher – und das ganz ohne künstliche Zusätze.

Natürlich und spürsam wirksam
von Martin B. vor 18 Tagen
Endlich eine Salbe, die nicht nur wärmt, sondern wirklich entspannt. Ich mag, dass sie rein natürlich ist – kein Brennen, kein chemischer Geruch. Bei meinen Nackenverspannungen das mit Abstand beste Produkt.

Rückenprobleme deutlich besser
von Karin S. vor 22 Tagen
Ich habe viele Cremes getestet – von Apotheke bis Drogerie. Keine kam an die Wirkung dieser Bienengift-Salbe heran. Der Rücken fühlt sich schon nach kurzer Zeit frei und leicht an.

Spürbare Wärme ohne Reizung
von Margarete W. vor 6 Tagen
Ich habe empfindliche Haut, und viele wärmende Cremes haben immer gebrannt oder Rötungen verursacht. Diese Bienengift-Salbe ist anders: Sie wirkt sanft, fühlt sich angenehm an und pflegt die Haut sogar. Besonders an kalten Tagen spüre ich, wie meine Finger und Gelenke wieder beweglicher werden. Ich benutze sie jetzt täglich – für mich das beste natürliche Mittel gegen Arthroseschmerzen.

Endlich wieder bewegliche Schulter
von Anja K. vor 11 Tagen
Wegen meiner Kalkschulter habe ich schon alles ausprobiert – von Wärmepflastern bis hin zu Schmerzcremes. Doch erst mit der API-REGENT®-Salbe kam echte Besserung. Sie zieht schnell ein, riecht kaum und wirkt tief – nach wenigen Tagen war die Bewegung in der Schulter viel freier. Mir gefällt besonders, dass das Bienengift aus echter Imkerei stammt und nicht industriell hergestellt wird.

Beste Regeneration nach dem Sport
von Lukas W. vor 15 Tagen
Ich laufe regelmäßig Halbmarathon und habe oft mit verhärteten Waden zu tun. Nach dem Training trage ich die Salbe auf, und man merkt sofort, wie die Muskeln lockerer werden. Kein Brennen, kein künstlicher Geruch – einfach natürliche Wärme und schnellere Erholung. Ich habe vorher Produkte aus der Drogerie probiert, aber die wirkten nur oberflächlich. Diese hier ist mit Abstand die beste.

Natürlich besser als alles andere
von Helmut P. vor 7 Tagen
Ich habe schon viele Bienengift-Salben getestet, weil ich unter Rheuma leide. Die meisten waren entweder zu scharf auf der Haut oder hatten kaum Effekt. Diese Salbe fühlt sich angenehm natürlich an und wirkt trotzdem stark – die Steifheit in meinen Fingern ist deutlich zurückgegangen. Ich nehme sie jetzt regelmäßig morgens und abends und bin wirklich überzeugt.

Kein Brennen, keine Zusätze - nur Wirkung
von Claudia H. vor 20 Tagen
Ich habe empfindliche Haut und reagiere auf viele Cremes mit Rötungen. Diese Bienengift-Salbe vertrage ich perfekt – sie ist mild, zieht schnell ein und wirkt richtig tief. Nach einer Woche war mein Nacken viel entspannter und die Beweglichkeit besser. Ich finde es großartig, dass sie natürlich ist und ohne Parabene oder Duftstoffe auskommt.

Spürbar mehr Beweglichkeit im Rücken
von Thomas F. vor 12 Tagen
Ich arbeite körperlich viel, und mein Rücken ist abends oft wie blockiert. Mit der API-REGENT®-Salbe merke ich schon beim Einreiben, wie die Wärme kommt und die Spannung nachlässt. Kein Fettfilm, kein starker Geruch – einfach angenehm natürlich. Ich hatte vorher zwei andere Bienengift-Produkte, aber die kamen nicht annähernd an diese Wirkung heran.

Mein Favorit unter allen Bienengift Salben
von Andreas F. vor 12 Tagen
Ich habe im Laufe der Jahre mehrere Bienengift-Salben ausprobiert, doch keine hatte diese Kombination aus natürlicher Zusammensetzung und echter Tiefenwirkung. Nach der Gartenarbeit ist sie meine erste Wahl – die Schultern entspannen sich sofort, und die Wirkung hält lange an. Ich finde es beruhigend, dass das Bienengift ethisch gewonnen wird und die Bienen dabei unversehrt bleiben. Für mich das beste Produkt auf dem Markt.
Was mir an Vitabay und Cardio TriProtect gefällt
- Es wird von einem seriösen Unternehmen in Deutschland produziert.
- Das Unternehmen wurde vor über 25 Jahren von einem deutschen Arzt gegründet und zählt zu den am besten bewerteten in ganz Europa.
- Nach der Bestellung bekam ich eine komplette Einweisung per E-Mail, das bedeutet, mir wurde ein persönlicher Ansprechpartner zugeteilt, der mir jederzeit bei Fragen zur Seite stand.
- Die Zusammensetzung macht sehr viel Sinn. Man merkt, dass bei der Entwicklung des Produktes die aktuelle Studienlage in Betracht gezogen wurde
- Vitabay bietet das Produkt zu einem absolut fairen Preis an. Andere Komplexe, die qualitativ weniger gut sind, kosten teilweise 70-80€ pro Monat. Cardio TriProtect gibt es bereits für 13,77€ pro Monat.
- Die Inhaltsstoffe bestechen durch höchste Reinheit und Qualität.
- Die Verpackung finde ich wunderschön.
- Ich habe alle Wirkstoffe einzeln, und kann mir sicher sein, dass ich auch das bekomme was auf der Verpackung steht.
- Weitere Positive Aspekte, die uns aufgefallen sind:
- 90 Tage Geld-Zurück-Garantie
- Extrem hilfreicher Kundenservice
- Das Gefühl, seine Gesundheit in die Hände von echten Experten zu legen!
Zum Angebot
Weitere Produkte die getestet wurden
Vorteile
Nachteile

Disclaimer: Diese Website stellt ein Portal dar, das Bewertungen und Informationen zu verschiedenen Marken und Unternehmen bereitstellt. Die Bewertungen sind auf der Grundlage des Ermessens unserer Autoren und sollten nicht als absolute Genauigkeitsmerkmale angesehen werden. Nahrungsergänzungsmittel sollten nicht als Ersatz für einen gesunden Lebensstil oder eine ausgewogene und abwechslungsreiche Ernährung angesehen werden. Bevor Sie Nahrungsergänzungsmittel einnehmen, insbesondere wenn Sie Medikamente einnehmen, unter ärztlicher Aufsicht stehen, schwanger sind oder stillen, sollten Sie einen Arzt konsultieren. Es ist wichtig zu beachten, dass die Informationen und Meinungen, die auf dieser Website präsentiert werden, lediglich als allgemeine Information dienen und keine bestimmten Ergebnisse garantieren.
